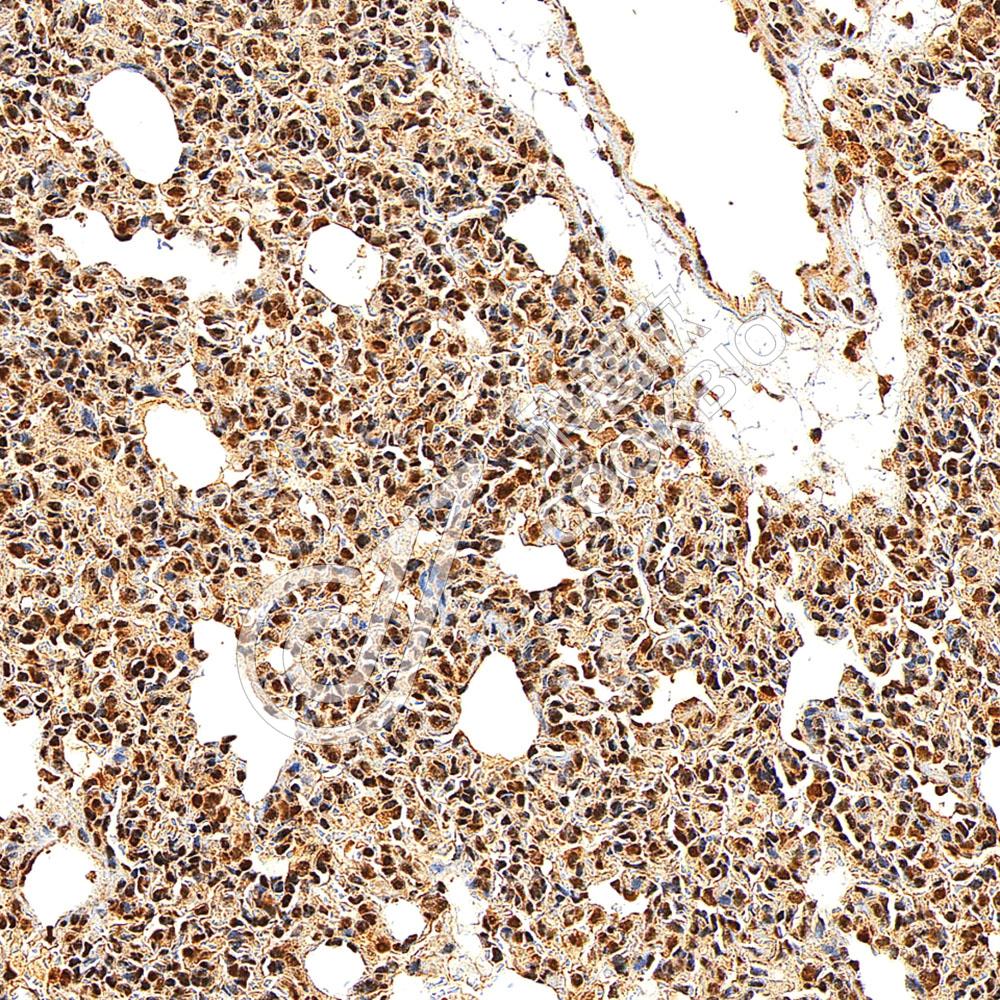

产品信息
| 蛋白质全称 | FAM78B蛋白 |
|---|---|
| 别名 | Protein FAM78B,FAM78B |
| Uniprot ID | Q8BQN5 |
| 免疫原 | KLH偶联的小鼠FAM78B合成肽 |
| 抗体亚型 | IgG |
| 纯化方式 | 亲和纯化 |
| 亚细胞定位 | 细胞质 |
应用
IHC/IF 免疫组织化学/免疫荧光
物种:人,小鼠,大鼠
稀释比:1:500-1:1500
阳性样品:食管癌, 肺, 睾丸
背景
Chromosome 1 is the largest human chromosome spanning about 260 million base pairs and making up 8% of the human genome. There are about 3,000 genes on chromosome 1, and considering the great number of genes there are also a large number of diseases associated with chromosome 1. Notably, the rare aging disease Hutchinson-Gilford progeria is associated with the LMNA gene which encodes lamin A. When defective, the LMNA gene product can build up in the nucleus and cause characteristic nuclear blebs. The mechanism of rapidly enhanced aging is unclear and is a topic of continuing exploration. The MUTYH gene is located on chromosome 1 and is partially responsible for familial adenomatous polyposis.
储存条件
储存条件:储存条件在:-20℃下储存一年, 避免反复冻融.
储存缓冲液:含0.15% ProClin300防腐剂, 100 μg/mL牛血清白蛋白和50%甘油的磷酸盐缓冲液.
图像

IHC检测FAM78B蛋白(货号 K1346011).
样品: 人食管癌, 4%多聚甲醛 (货号KSG1101) 固定12-24小时.
抗原修复: Tris-EDTA抗原修复液(pH 9.0) (KSG1203), 98℃, 20分钟.
—抗: 1: 1000稀释, 4℃ 孵育过夜.
二抗: S-vision免疫组化多聚二抗(山羊抗兔),即用型 (货号KB3906), 室温孵育20分钟.
样品: 人食管癌, 4%多聚甲醛 (货号KSG1101) 固定12-24小时.
抗原修复: Tris-EDTA抗原修复液(pH 9.0) (KSG1203), 98℃, 20分钟.
—抗: 1: 1000稀释, 4℃ 孵育过夜.
二抗: S-vision免疫组化多聚二抗(山羊抗兔),即用型 (货号KB3906), 室温孵育20分钟.

IHC检测FAM78B蛋白(货号 K1346011).
样品: 小鼠睾丸, 4%多聚甲醛 (货号KSG1101) 固定12-24小时.
抗原修复: Tris-EDTA抗原修复液(pH 9.0) (KSG1203), 98℃, 20分钟.
—抗: 1: 1000稀释, 4℃ 孵育过夜.
二抗: S-vision免疫组化多聚二抗(山羊抗兔),即用型 (货号KB3906), 室温孵育20分钟.
样品: 小鼠睾丸, 4%多聚甲醛 (货号KSG1101) 固定12-24小时.
抗原修复: Tris-EDTA抗原修复液(pH 9.0) (KSG1203), 98℃, 20分钟.
—抗: 1: 1000稀释, 4℃ 孵育过夜.
二抗: S-vision免疫组化多聚二抗(山羊抗兔),即用型 (货号KB3906), 室温孵育20分钟.
IHC检测FAM78B蛋白(货号 K1346011).
样品: 大鼠肺, 4%多聚甲醛 (货号KSG1101) 固定12-24小时.
抗原修复: Tris-EDTA抗原修复液(pH 9.0) (KSG1203), 98℃, 20分钟.
—抗: 1: 1000稀释, 4℃ 孵育过夜.
二抗: S-vision免疫组化多聚二抗(山羊抗兔),即用型 (货号KB3906), 室温孵育20分钟.
样品: 大鼠肺, 4%多聚甲醛 (货号KSG1101) 固定12-24小时.
抗原修复: Tris-EDTA抗原修复液(pH 9.0) (KSG1203), 98℃, 20分钟.
—抗: 1: 1000稀释, 4℃ 孵育过夜.
二抗: S-vision免疫组化多聚二抗(山羊抗兔),即用型 (货号KB3906), 室温孵育20分钟.
需要技术支持?
如果您有任何问题或如果您在实验过程中遇到问题,或需要更详细的技术指导,请联系我们的技术支持团队
 400-6027-270
400-6027-270
联系我们
如果您对我们的公司或产品有任何疑问,欢迎随时联系我们





















 湖北省武汉市东湖新技术开发区高新二路388号生物医药加速器22栋5楼
湖北省武汉市东湖新技术开发区高新二路388号生物医药加速器22栋5楼  400-6027-270
400-6027-270  鄂公网安备42018502008544号
鄂公网安备42018502008544号